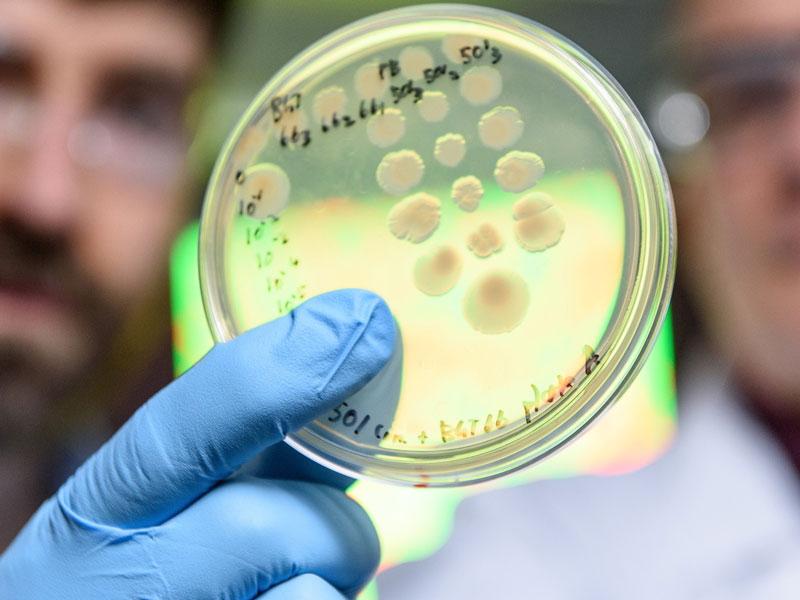
cholera

أقسام المستشفى
مستشفى حاصبيا جاهز لاستقبالكم بمختلف أقسامه ليقدّم لكم رعاية صحيّة شاملة ومتكاملة

قسم الطوارئ

قسم الأشعّة

قسم المختبر

العيّادات الخارجية

قسم غسيل الكلى

قسم الإستشفاء والجراحة
قسم خاص بمرضى الكوليرا

قسم التّوليد

قسم الأطفال

قسم العمليّات

قسم العناية الفائقة

قسم التّعقيم
26+
طبيب متخصّص




